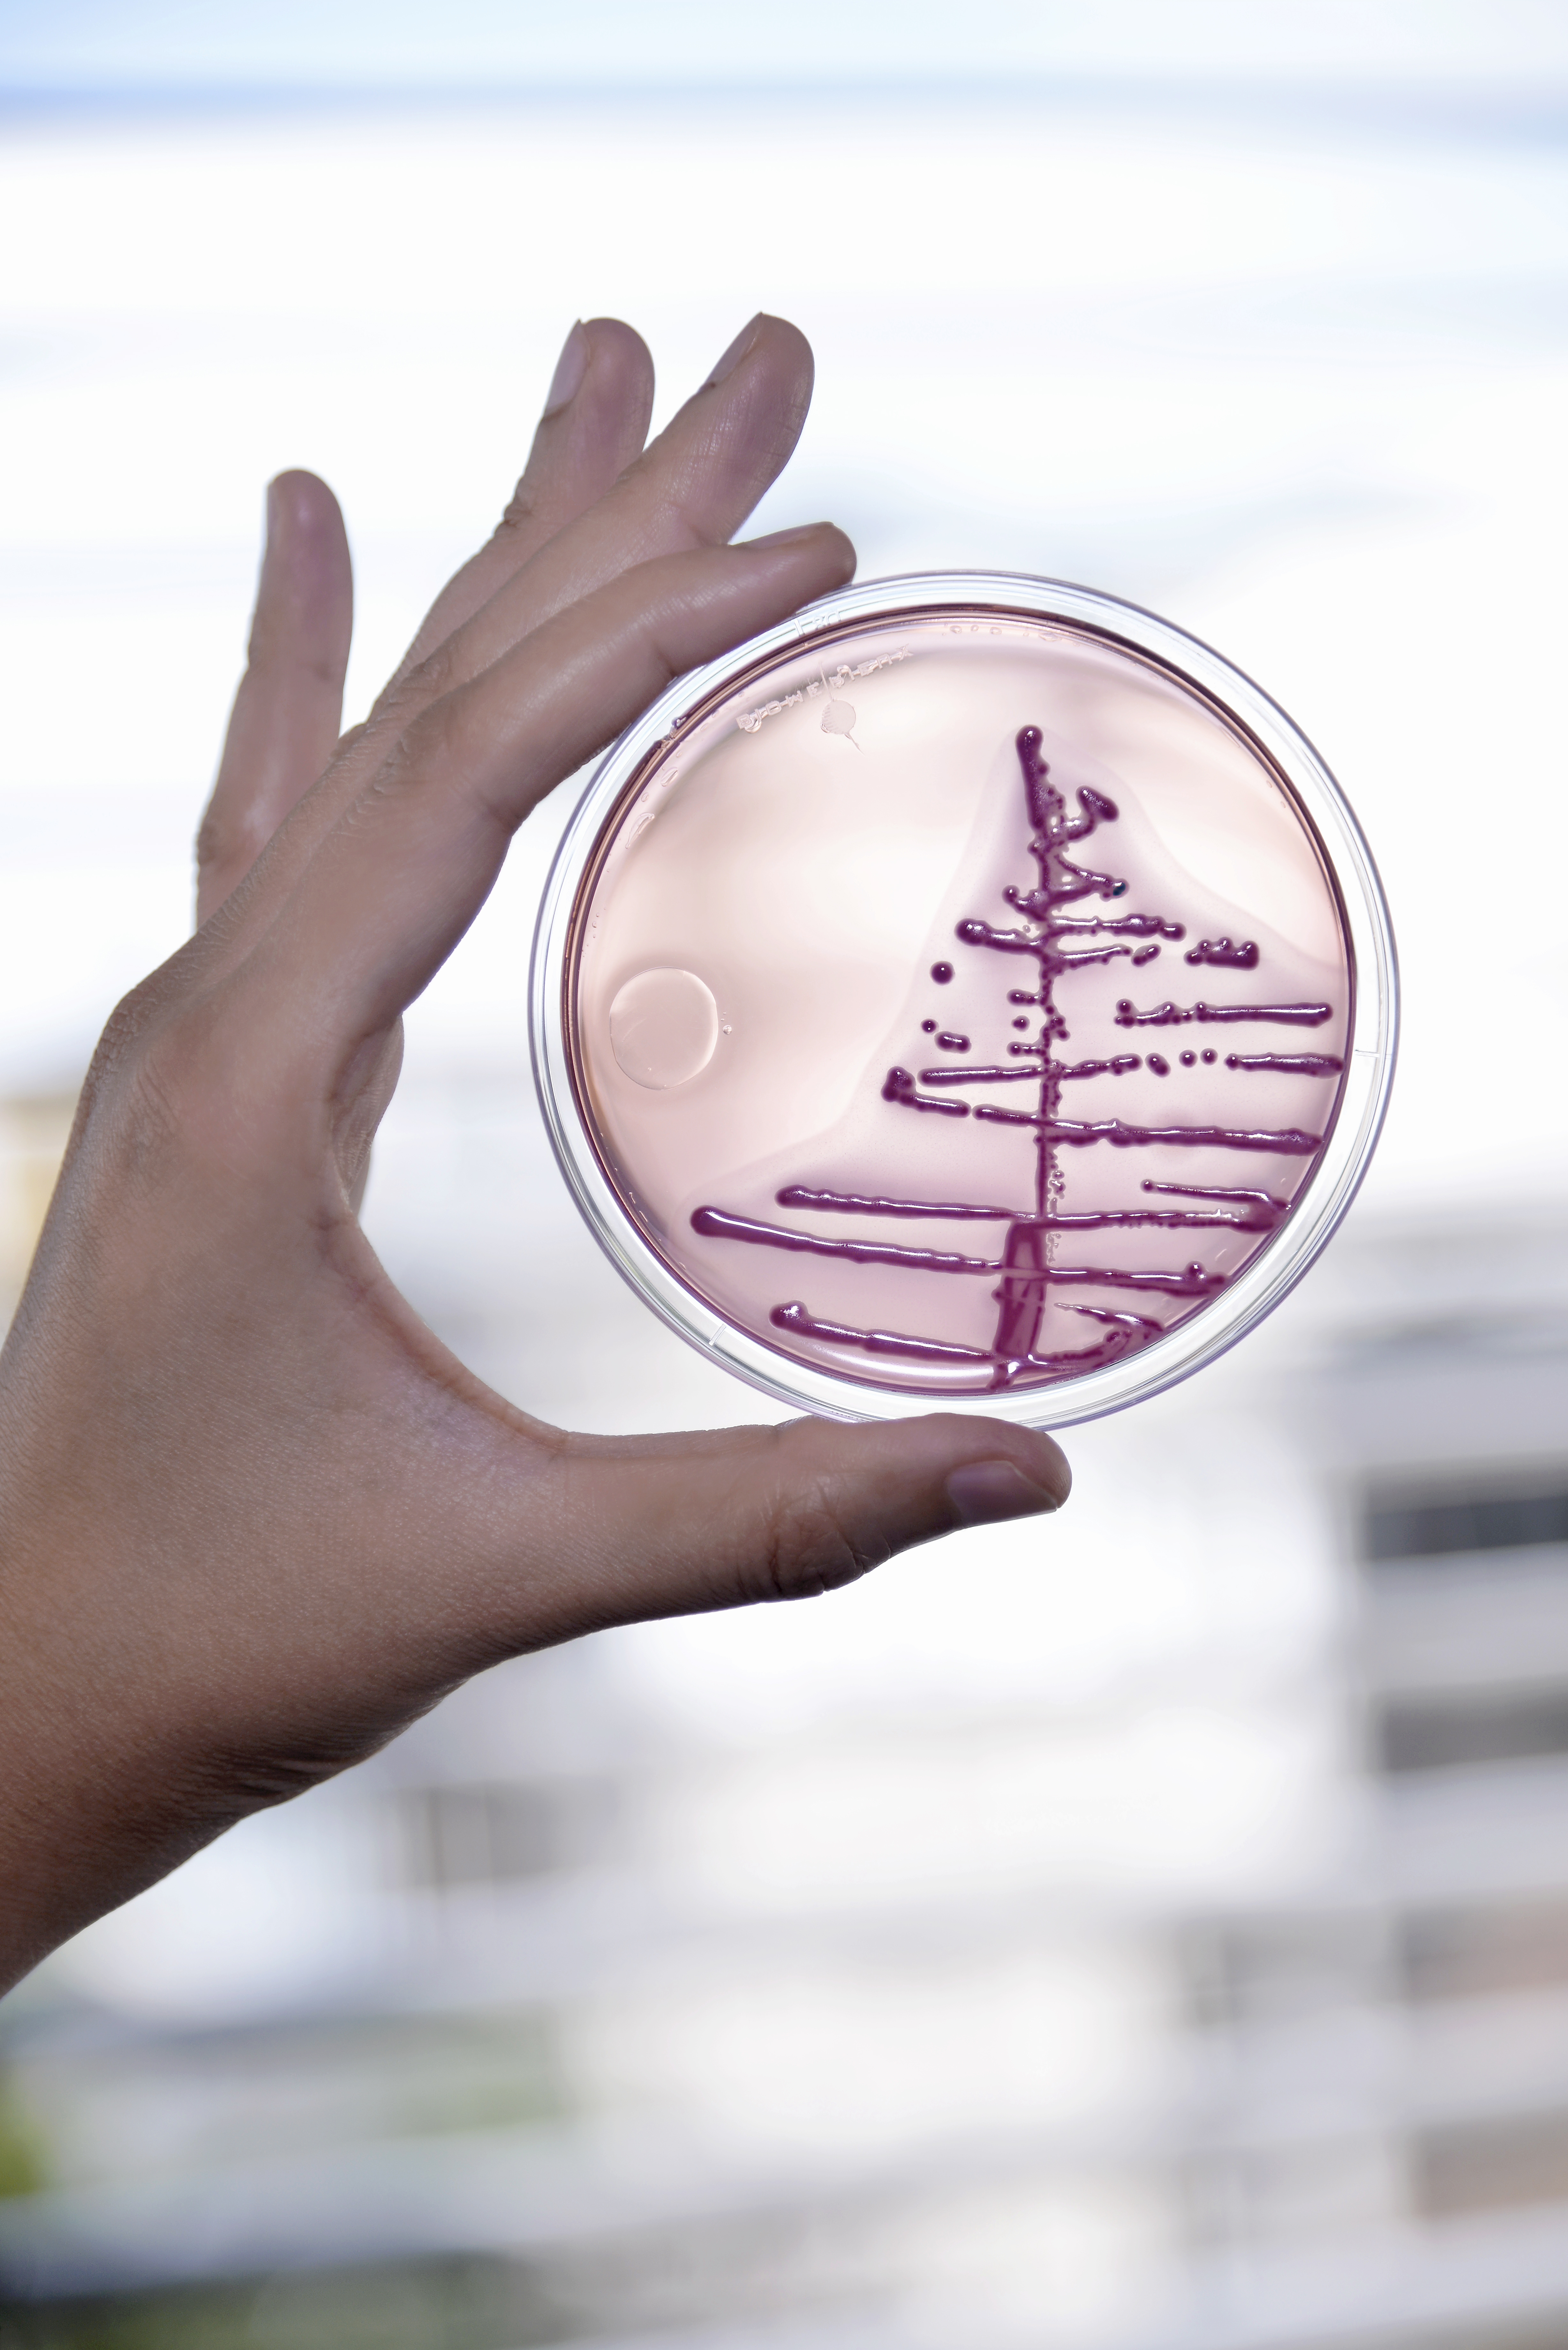

Quiz Mars Bleu
_
Mars Bleu est le mois de la sensibilisation au dépistage du cancer colorectal.
A cette occasion, testez vos connaissances sur le sujet en répondant à ce rapide quiz!